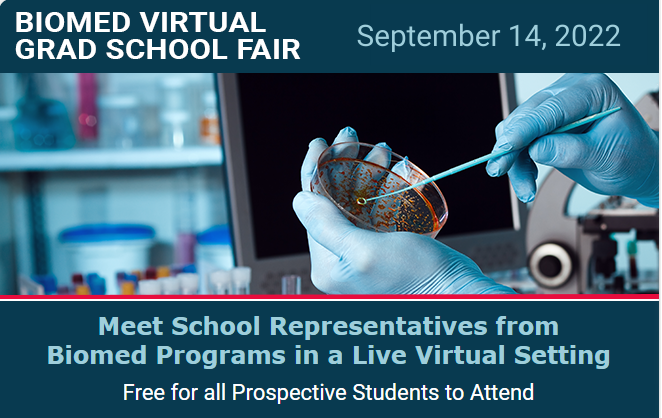
USF MCOM Graduate Programs tweet media

Whether it's going for a walk, baking, or watching another episode of your favorite comfort show you've seen millions of times, find time today to do it!
.
.
#wellnesswednesday #wellness #takeamoment #mentalhealth #reminder #break #usf #usfgrad #tampabay

English